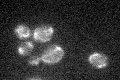
YPR047W

View description
Mitochondrial phenylalanyl-tRNA synthetase, active as a monomer, unlike the cytoplasmic subunit which is active as a dimer complexed to a beta subunit dimer; similar to the alpha subunit of E. coli phenylalanyl-tRNA synthetase
Localization:
Intensity:
Fold change:
Significance:
-
C’ GFP library in SD

mitochondria22.51 -
N' NOP1pr-GFP in SD

mitochondria83.3833 -
N' TEF2pr-mCherry in SD

mitochondria0 -
N' NATIVEpr-GFP in SD

mitochondria16.2732 -
N' TEF2pr-VC and Cyto-VN in SD

#N/A0 -
C’ GFP library in SD+DTT

mitochondria33.221.47Yes -
C’ GFP library in SD+H2O2
mitochondria25.411.12No -
C’ GFP library in Starvation Media

mitochondria21.20.94No -
C’ GFP library on the background of Pup2-DaMP

mitochondria -
C’ GFP library on the background of CCT mutant

mitochondria24.28631.07839No
